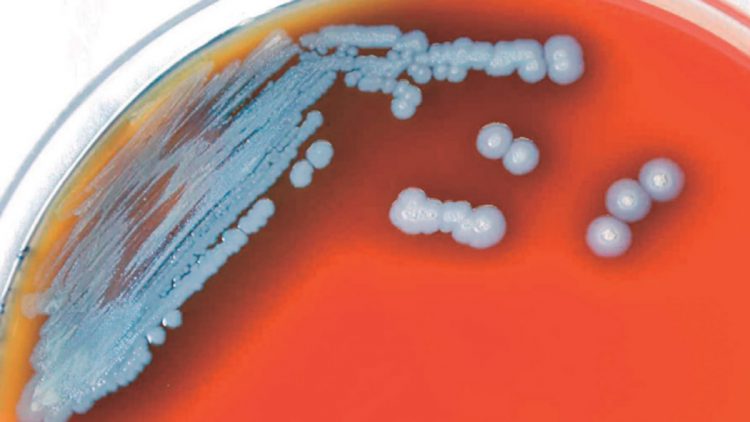
Detectan bacteria mortal en agua y suelo de EU

El Centro para el Control y la Prevención de Enfermedades alertó del hallazgo a los médicos y expertos en salud pública de todo el país
AGENCIAS Washington, DC.- Una bacteria potencialmente mortal se encontró por primera vez en muestras de agua y suelo en Estados Unidos, lo que llevó al Centro para el Control y la Prevención de Enfermedades a alertar a los médicos y expertos en salud pública de todo el país este miércoles para que la tengan en cuenta al examinar a los pacientes.
La bacteria, Burkholderia pseudomallei, fue detectada en la región de la Costa del Golfo del sur de Mississippi.
La exposición a la bacteria puede causar melioidosis, una “enfermedad rara y grave”, según el CDC; aproximadamente una de cada 4 mil 600 personas expuestas tiene la enfermedad, según un estudio de 2019.
El estudio también encontró que alrededor de 90 mil personas mueren anualmente a causa de la melioidosis. “Una vez que está bien establecida en el suelo, B. pseudomallei no puede eliminarse del suelo de manera factible”, el CDC escribió en su aviso de salud.
“Los esfuerzos de salud pública deben centrarse principalmente en mejorar la identificación de casos para que se pueda administrar el tratamiento adecuado”.
Las muestras nos dicen que la bacteria ha estado presente en la región de Mississippi desde al menos el 2020, cuando se descubrió que una persona en la región de la costa del Golfo tenía melioidosis, aunque no está claro exactamente cuánto tiempo ha estado Burkholderia pseudomallei, también conocida como B. pseudomallei. en la zona del estado.
La bacteria se ha encontrado previamente en regiones con climas tropicales y subtropicales de todo el mundo, como el sur y sureste de Asia, el norte de Australia y partes de América Central y del Sur.
El CDC dijo que el modelado mostró que el clima del sur de Mississippi también era propicio para cultivar la bacteria.